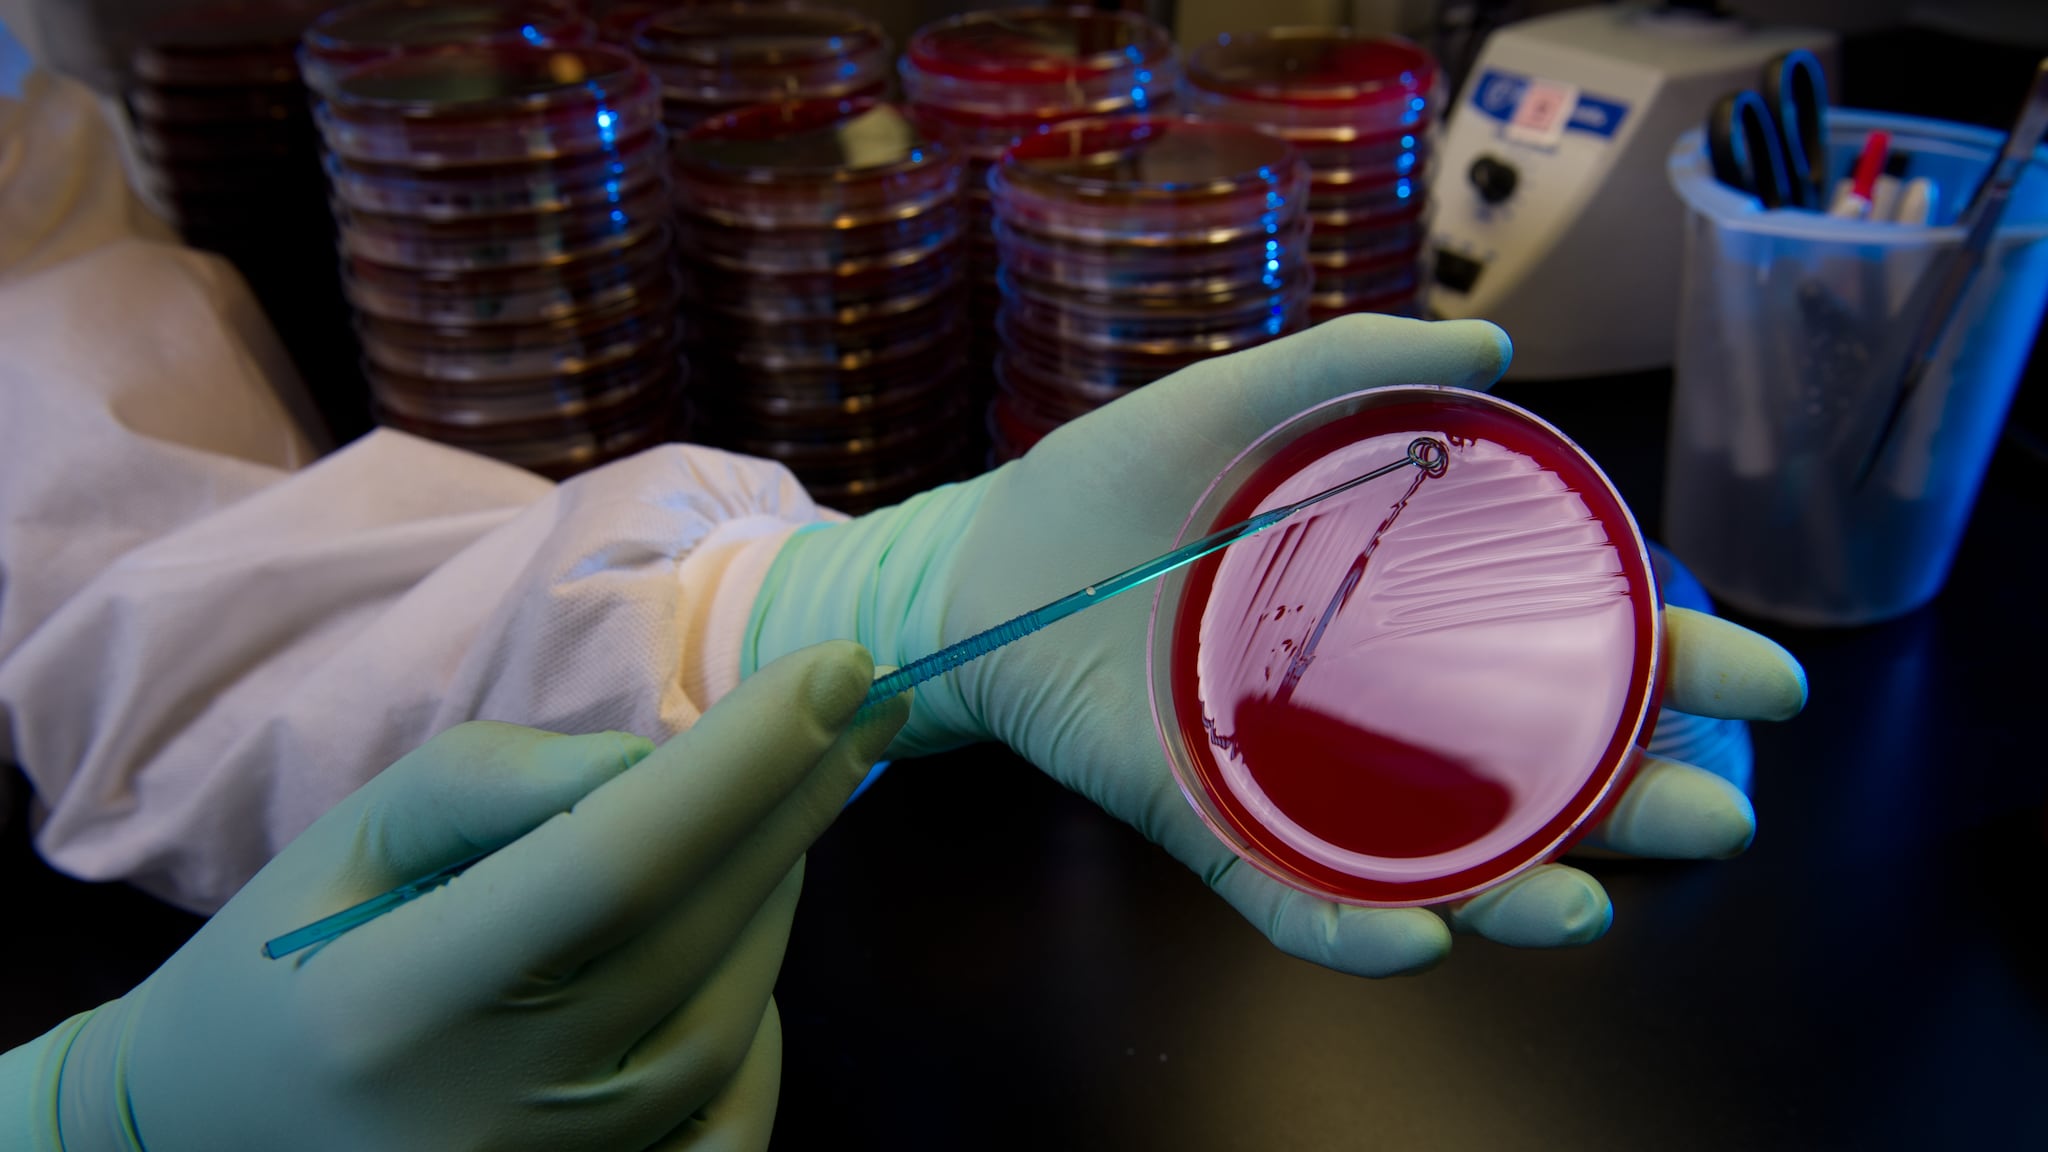
Culture of Streptococcus Lab staff culture Streptococcus.

Key points
- The Active Bacterial Core surveillance (ABCs) Isolate Bank is an extensive collection of isolates for ABCs pathogens.
- CDC maintains isolates in a climate-controlled storage facility.
- Institutions can request isolates through a formal request system.
Overview
The ABCs Isolate Bank is a joint project of CDC's Division of Bacterial Diseases, the National Center for Immunization and Respiratory Diseases, and the CDC Biorepository.
ABCs sites send bacterial isolates from a normally sterile site (e.g., blood, cerebrospinal fluid) to CDC for antibiotic susceptibility testing and serotyping.
Importance of the isolate bank
The ABCs Isolate Bank contains carefully collected and preserved isolates and crucial laboratory, clinical, and demographic data. These data help further research in a variety of fields, without typical limitations. This isolate bank offers unique research opportunities to investigate scientific questions beyond routine surveillance.
Storing, shipping, and handling isolates
CDC stores isolates in a restricted-access facility in Lawrenceville, Georgia, with computerized climate control sensors. Staff provide regular 24-hour monitoring for all specimen storage units. Staff carefully monitor and use detailed care throughout the shipping and handling process.
Holiday shipping schedule
No orders will be shipped from December 17, 2024 to January 6, 2025.
Requesting access to isolates
ABCs Isolate Bank custodians review requests for isolates prior to approval and release. CDC strictly enforces a limited distribution policy that prohibits the secondary distribution of ABCs isolates to third-party researchers. There may be a cost associated with isolate requests from for-profit institutions.
For more information on isolate availability and data, please review Available Isolates and Antimicrobial Susceptibility Testing.
